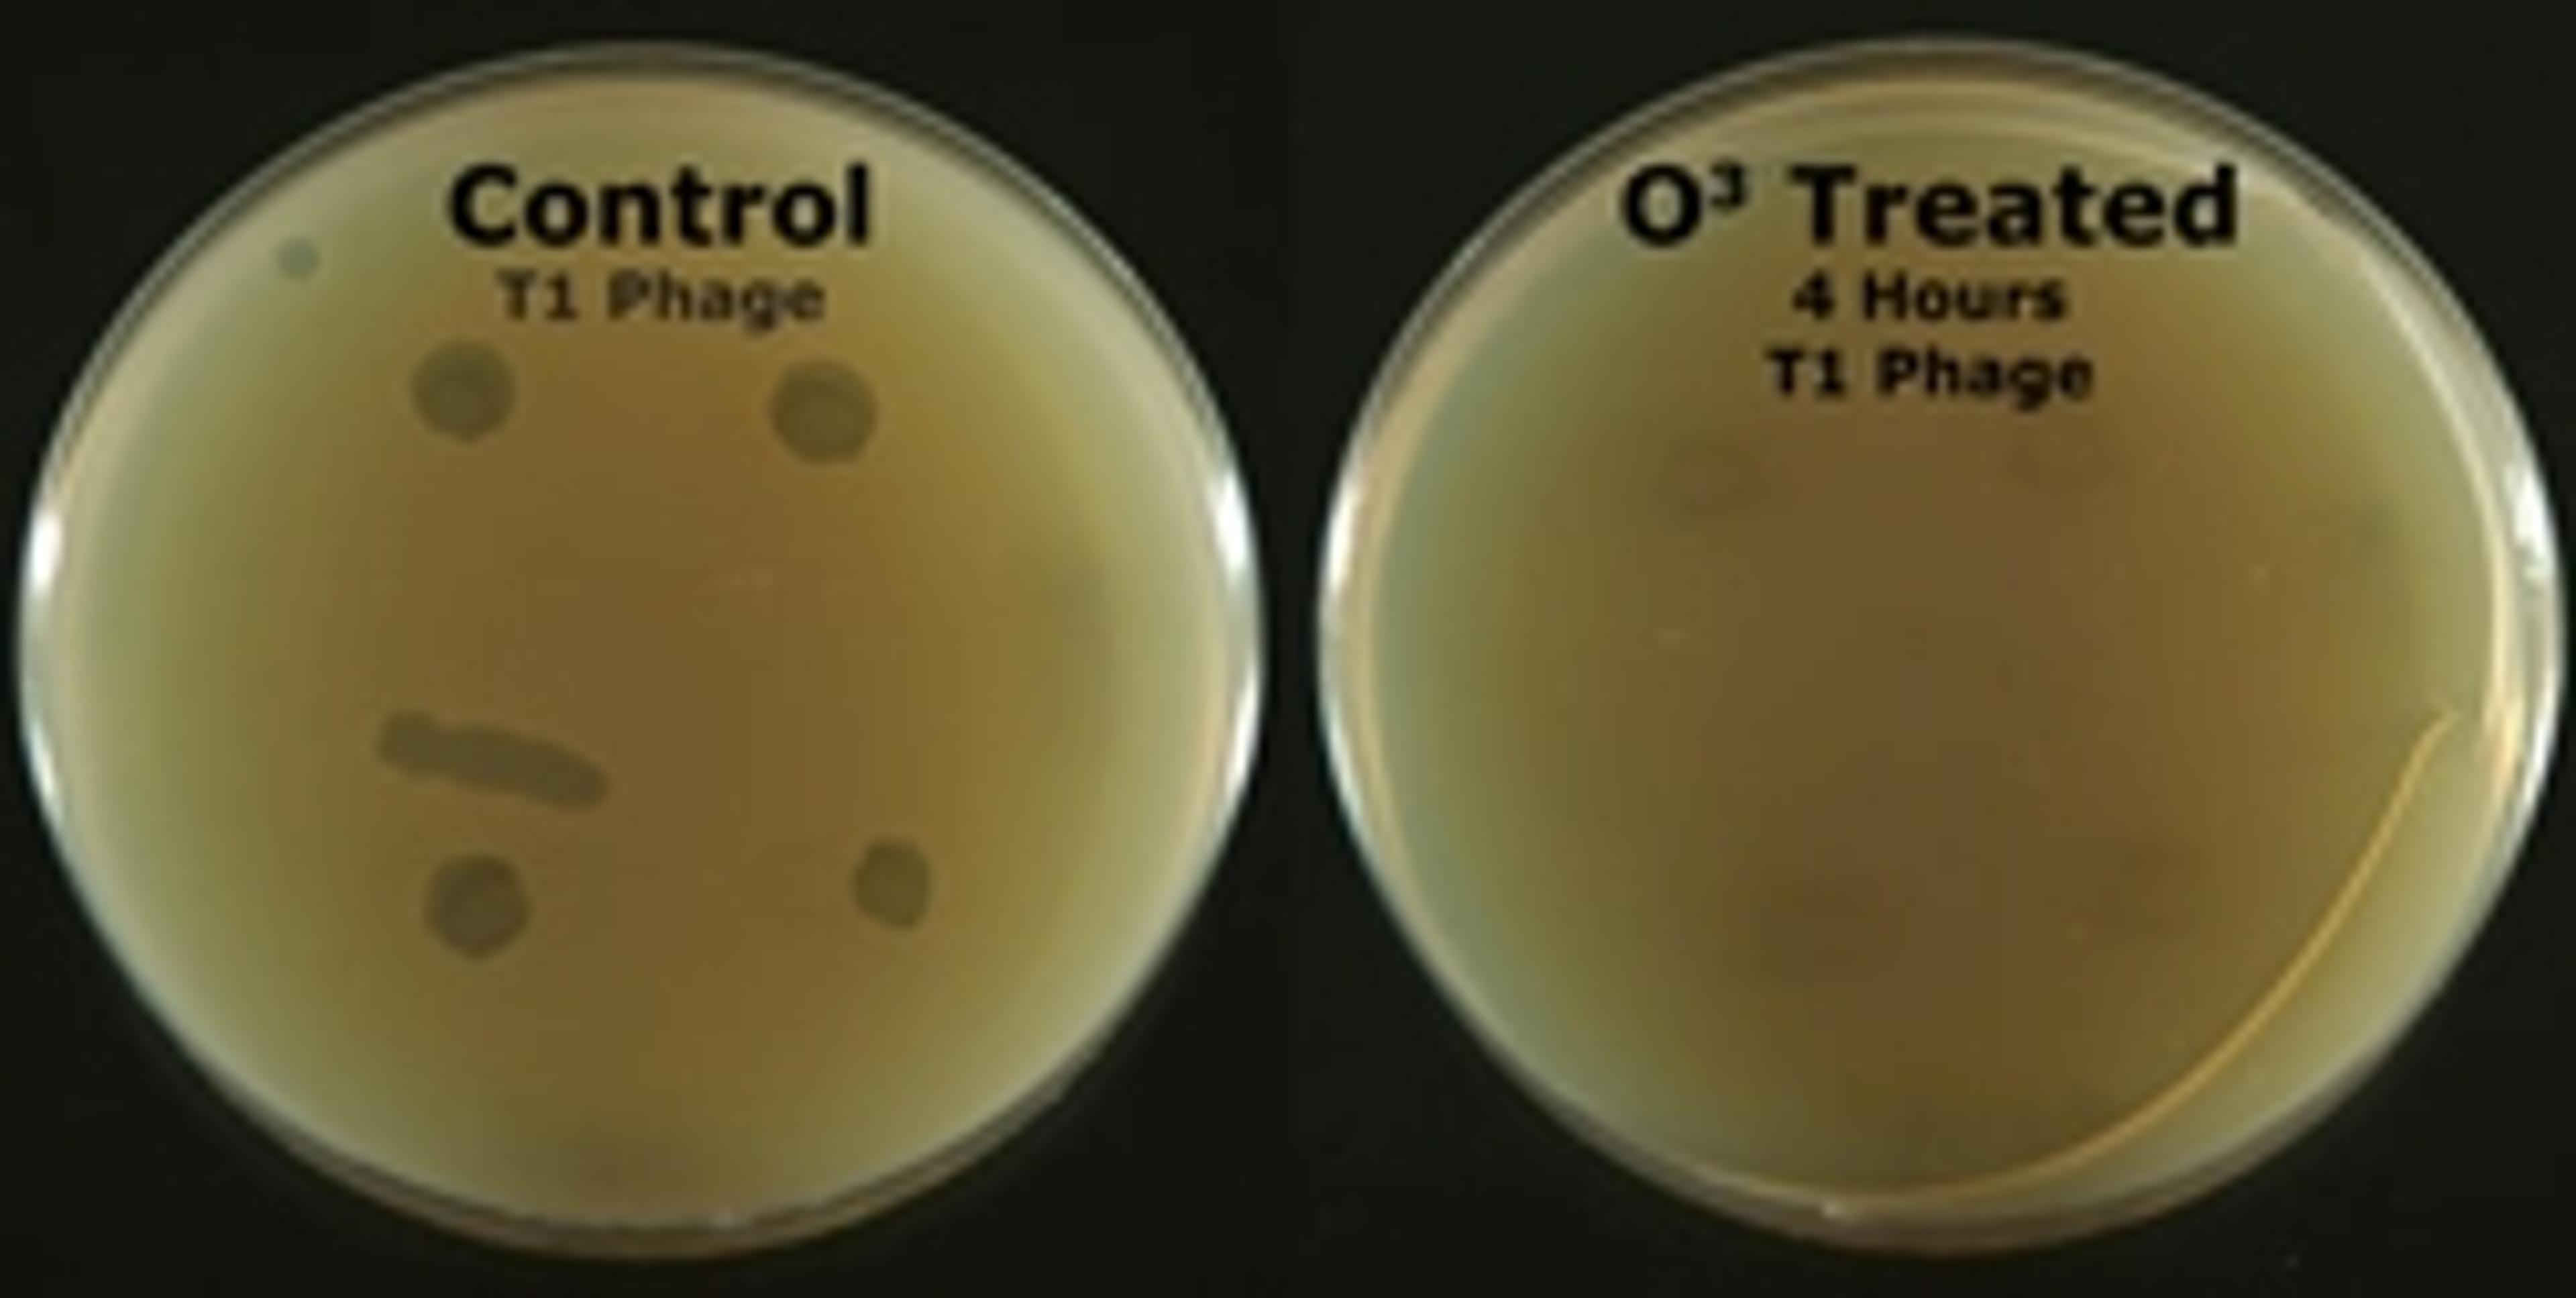

Product News
News & Articles
25
Selected Filters:
Product News
Diverse Pharmacological Modulators for Targets, Pathways and Processes
AMSBIO has announced the launch of PATHM2 small molecules libraries for small scale screening in developmental biology and discovery research.
Industry News
Adeno-Associated Virus Services for Gene Delivery
AMSBIO has introduced an expanded range of Adeno-associated virus (AAV) cloning and packaging services
Product News
Exosomes for Regenerative Medicine Research
Product News
Ebola Antigens and Antibodies for ELISA
Industry News
Fluorescence-Based Mitochondria / Metabolism Assays
Product News
Easy-to-Use Quantitative Gamma-H2AX Assay
Industry News
Cancer Conference Poster Prize Winner
Industry News